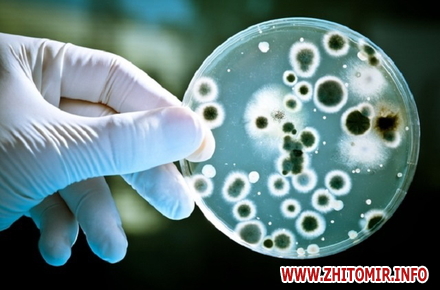

Останні кілька тижнів українці, які відпочивають у Туреччині, активно діляться інформацією про поширення вірусу Коксакі, що супроводжується сильним жаром і висипаннями на тілі. В основному хворіють діти.
Стурбовані збільшенням випадків захворюваності на цю недугу і житомиряни. Зокрема, користувачка Ірина Коцюба близько тижня тому написала в соцмережі, що деяких житомирян туроператори відмовляють летіти до Туреччини через Коксакі.
«Мені вже більше тижня всі розповідають про цей вірус. Туроператори відмовили летіти до Турції, а багатьох даже не попередили, хоча всі туристичні фірми про це знають. А тепер чекаємо цей вірус у нас з поверненням всіх українців з відпочинку», - написала Ірина Коцюба.
Коксакі відноситься до ентеровірусів. «Це кишковий» вірус, що активізується влітку, особливо в спеку, - йдеться в повідомленні Житомирського обласного медичного центру здоров’я та спортивної медицини.
У публікації зазначається: віруси Коксакі розмножуються в шлунково-кишковому тракті людини і відносяться до групи РНК-вірусів. Вперше їх було виділено з фекалій хворих дітей з синдромом поліомієліту в одному з госпіталів американського міста Коксакі, тому вони отримали таку назву.
«Зазвичай вірус Коксакі привозиться з місць відпочинку. Велике скупчення дітей, відвідування дитячого клубу, купання в басейнах і море сприяють широкому поширенню захворювання. Батьки сприймають прояви захворювання за звичайні перегрів на сонці або застуду, особливо в разі слабкої симптоматики або безсимптомного протікання хвороби. Вірусом Коксакі найчастіше хворіють діти більш старшого віку або немовлята. Захворювання найчастіше виникає в осінні або літні місяці. Основні механізми передачі вірусів Коксакі — фекально-оральний і контактний (з виділенням носоглотки)», - йдеться у повідомленні медичного центру здоров’я.
Висока контагіозність вірусу сприяє поширенню захворювань в місцях скупчення дітей (санаторіях, курортах, дошкільних навчальних закладах).
Від моменту зараження до прояву симптомів хвороби проходить від 2 до 10 днів (інкубаційний період в межах 7 днів). Початок хвороби гострий, супроводжується лихоманкою (температура до 39 – 40 градусів Цельсія), може ускладнюватися головним болем, блювотою. Крім того, спостерігається почервоніння горла, жовтуватий наліт на язиці, збільшення лімфатичних вузлів. Ці симптоми тримаються до 2 днів, після чого на тілі хворого з'являється характерне висипання. Ротова порожнина запалюється покривається пухирями, на тілі також появляється висипка, особливо на сідницях, на ступнях та кистях рук появляються невеликі червонуваті, плоскі плями або пухирі.
Захворювання ступнів, кистей рук та ротової порожнини не є дуже важким захворюванням, тому більша кількість дітей старшого віку та немовлят одужують без різних ускладнень.
Через стертість симптомів та запізнілої появи пухирців, захворювання вірусом Коксакі часто плутають зі звичайною застудою або ГРВІ, списуючи потім появу висипу на алергічні реакції. Найчастіше батьки дізнаються про те, що дитина перехворіла саме вірусом Коксакі через 3 місяці, коли на руках і ногах починають злазити нігті. Така зміна нігтьових пластинок – ще один симптом Коксакі, хоча і запізнілий.
Вірус Коксакі іноді може призвести до запалення центральної нервової системи, вірусного менінгіту, які проходять самостійно.
При появі симптомів захворювання, особливо якщо в регіоні спостерігається спалах інфекції, не слід приводити дітей до лікувального закладу. Необхідно викликати лікаря додому, щоб уникнути подальшого поширення вірусу. Однак лікування буде призначене симптоматичне, адже специфічних ліків від цього вірусу не існує.
Особливих заходів по боротьбі з вірусом не розроблено, - констатують фахівці. Вірус Коксакі вкрай заразний, передається повітряно-крапельним шляхом та в результаті попадання в стравохід через забруднені руки і продукти. Під час епідемічного підйому захворюваності сприйнятливість дітей до вірусу вкрай велика, особливо серед дітей, які жодного разу не хворіли. Після перенесеної інфекції імунітет не виробляється, тому заразитися можна повторно. Однак вторинне протікання інфекції переноситься легше.
Величезне значення в профілактиці цього захворювання має виховання гігієнічних навичок у дітей. У якості профілактичного заходу досить дієвим є недопущення відвідування дитиною місць скупчення людей. Краще на деякий час відмовитися від відвідування дитячого садка, культурно-масових заходів, поліклінік. Найважливіше значення має ізоляція хворого на 7-10 днів з моменту появи перших симптомів.
Основними заходами профілактики є санітарно-гігієнічні заходи, посилення контролю за питним режимом і харчуванням.
1. З метою ранньої діагностики і своєчасної ізоляції хворих необхідно проводити щоденні медичні огляди (при прийомі дітей), спостереження за контактами дітьми з оглядом шкіри, слизової зіву, з вимірюванням температури тіла.
2. Забезпечити достатню кількість термометрів і шпателів на кожну дитину групи (класу).
3. При появі перших випадків захворювання протиепідемічні заходи в дитячих колективах проводяться протягом 7 днів.
4. У групу, де було виявлено випадки захворювання, припиняється прийом нових дітей, переведення дітей і персоналу з групи в групу на період спостереження.
5. У випадках масового поширення захворювання слід заборонити проведення масових дитячих заходів;
6. Дезінфекційні заходи в осередках проводяться, як при гепатиті А.
7. Посилюються режими провітрювання і кварцювання в групах.
8. Збільшити перебування дітей на свіжому повітрі з виділенням окремої площадки для групи, де було виявлено випадки захворювання;
9. Проводити санітарно-освітню роботу з профілактики ентеровірусної інфекції з персоналом та батьками.
Дане захворювання неможливо попередити, якщо не вважати виключення контактів із забрудненою водою та інфікованими людьми, - зазначають фахівці.
Які курорти для літнього відпочинку обирають житомиряни, читайте тут.
























